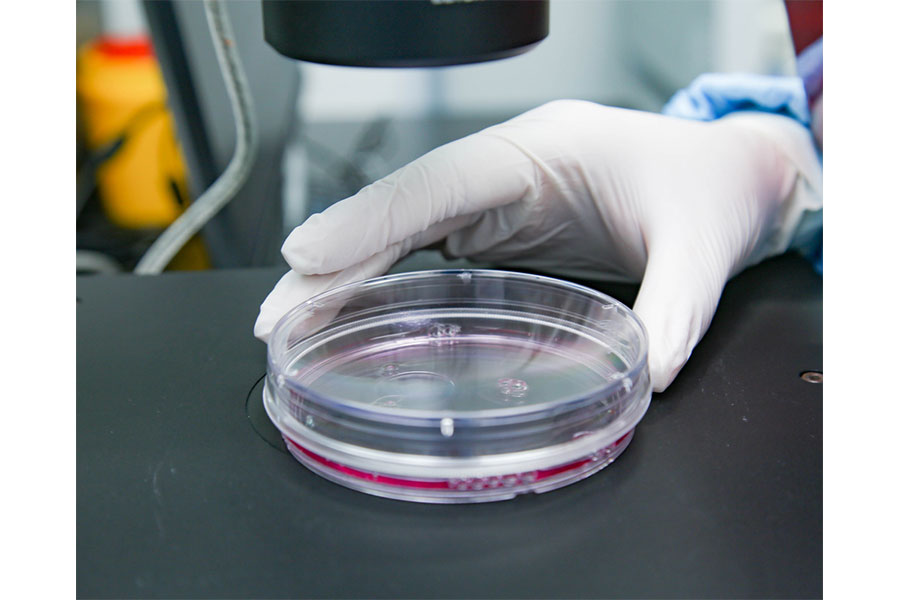

百欧派(天津)生物技术有限公司位于天津市津南区海河创意中心,是一家以宠物为服务对象、以干细胞和免疫细胞为主要研发方向的生物科技公司,注册资本为6600万人民币,拥有1000平方米的标准化干细胞研发平台。
百欧派以“科研为本、质量为先、人才为重”的理念为指导,致力于打造宠物干细胞和免疫细胞科技领域的领航者。为此,公司聘请了院士和国内外知名专家组成专家委员会,为公司的战略定位提供咨询和建议。
百欧派与西北农林科技大学强强联合,成立了国内首家宠物干细胞研究院,并组建了以专家博士领衔、博硕士为核心的研发团队。团队以最前沿的细胞疗法新技术为宠物健康事业提供精准服务,并在宠物间充质干细胞制剂的基础上,成功研发出犬Ⅰ型糖尿病、Ⅱ型糖尿病干细胞治疗技术和宠物NK细胞、DC细胞治疗技术。
此外,百欧派依托公安部上海特种犬基地,成立三羊泰(上海)生物技术有限公司,开展特种犬干细胞、免疫细胞抗衰老技术研发,致力于延长宠物寿命,提升宠物生活质量。同时,公司创建了首家宠物干细胞临床医学中心,目标是建设以细胞疗法为特色的高水平宠物医院,为宠物提供更优质的治疗服务。
百欧派在宠物干细胞和免疫细胞科技领域取得了一系列显著成果,展示了公司在该领域的实力和市场前景。未来,百欧派将继续推动宠物健康事业的发展,为打造更美好的宠物生活贡献力量。
主要产品:干细胞和免疫细胞技术研发和应用

京公网安备 11010502043458号